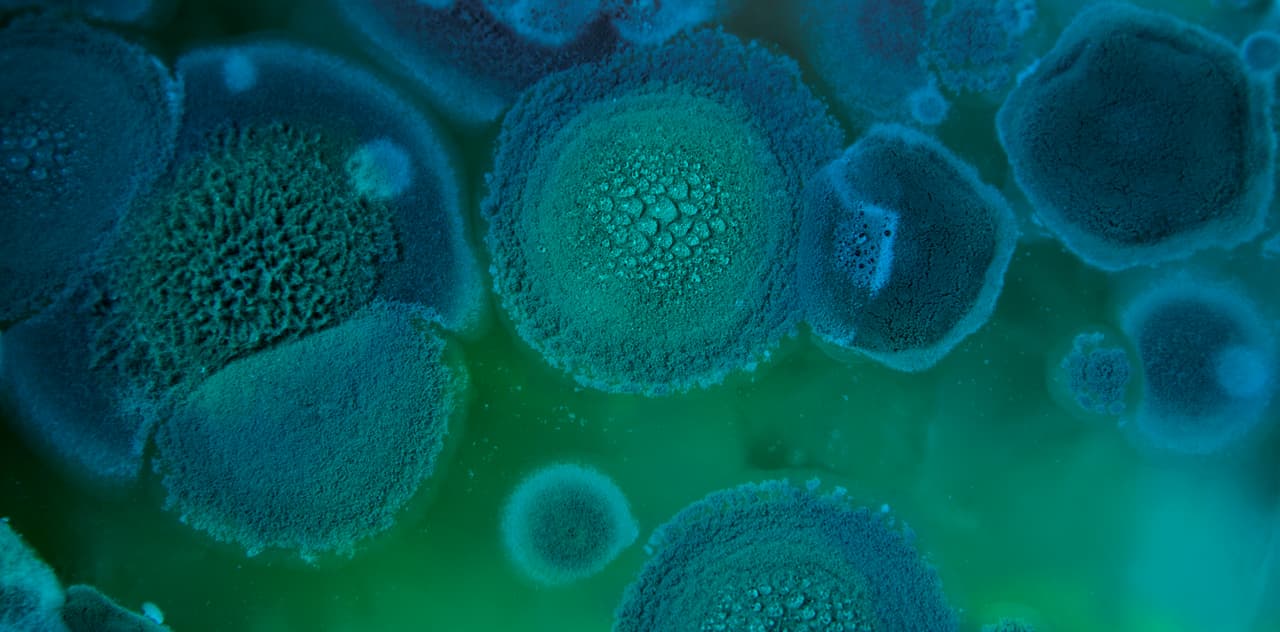
¿Un archipiélago de islas en un mar verde esmeralda? No. Estas son colonias del hongo
<i>Aspergillus fumigatus</i>.

Planeta
1/13
2/13
3/13
4/13
5/13
6/13
7/13
8/13
9/13
10/13
11/13
12/13
13/13
¿Puedes adivinar de qué se tratan estas imágenes de texturas naturales?
La naturaleza se nos presenta en en una inmensa diversidad de formas y colores. A veces, los mismos patrones se repiten en cosas gigantes y minúsculas. En el restringido recuadro de una fotografía, puede parecer lo mismo una imagen tomada desde una avión que a través de un microscopio. Sin leer las respuestas debajo de cada imagen, trata de adivinar a qué corresponden estas imágenes.

¿Es este un vistoso platillo con hojas de alcachofas o una obra de arte con pétalos de rosas? No es ninguna de estas. Estas son las escamas de un pescado.
iStock
¿Un archipiélago de islas en un mar verde esmeralda? No. Estas son colonias del hongo Aspergillus fumigatus.
iStock
¿Es esto un arrollo que corre entre rocas? No. Es una vista acercada a las vetas en el tronco de un árbol.
iStock
¿Un laberinto sin salida? No y tampoco es un cerebro petrificado... Se trata del esqueleto de carbonato de calcio de un coral.
iStock
¿Ves un artístico vitral en esta imagen? Pues no es eso. Así se ve la pulpa de una mandarina con la luz de fondo. Seguro no apreciabas hasta ahora que este cítrico no solo es deliciosa sino también bello.
iStock
¿Un bello paisaje coralino? No. un alimento completamente cubierto de moho. Hasta el infortunio gastronómico tiene su belleza.
iStock
¿Resmas de papel?¿plumas? No. Esta es la vista desde abajo de un hongo donde se ve su himenio laminado.
iStock
¿No parece esto un delicioso jabón artesanal? Pues no. Pero sí es lo que limpiarías con él. Esto es un acercamiento a la piel humana.
iStock
¿Un arrecife de coral junto a la costa? No. Un corte de una bella piedra semipreciosa, ágata.
iStock
¿Es este un mapa de caminos entre campos de cultivo? NEste mapa no te llevaría a ningún sitio. Lo que vemos aquí es una vista bien de cerca de una hoja de laurel. Cada línea es una de sus venas. También se ven los compartimentos llenos de clorofila.
iStock
¿Esto se te parece un postre helado con pepitas de chocolate? Pues no te confíes a degustarlo porque también es otra forma de hongo, el moho negro.
iStock
¿El camino a la dimensión desconocida? Este espiral puede inspirar todo tipo de ideas pero es sencillamente el corte al medio de una cebolla.
iStock
¿Y esta colección de gemas? En realidad es arena vista con gran aumento. Ya no volverás a caminar por la playa sin apreciar la belleza que estás pisando.
iStockRelacionados: